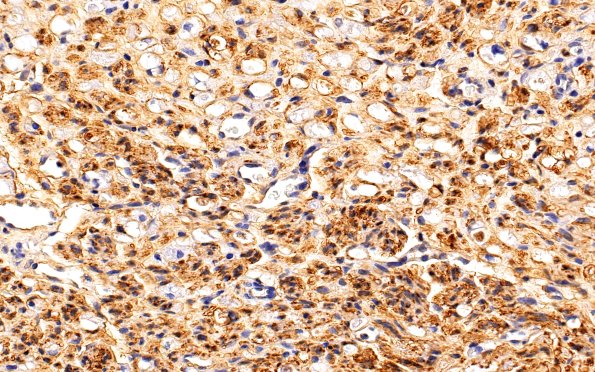
3B2 Nerve fibers (Case 3) S100 40X

Table of Contents
Washington University Experience | PERIPHERAL NEUROPATHY | 1 NORMAL NERVE ANATOMY | 2 Normal IHC | 3B2 Nerve fibers (Case 3) S100 40X
There is strong and diffuse S100 immunostaining of Schwann cells associated with all sizes of axons in the normal sural nerve. The unmyelinated Schwann cells demonstrate a more solid pattern and the myelinated axons more of a rim pattern that corresponds with the amount and distribution of Schwann cell cytoplasm. (S100 IHC)